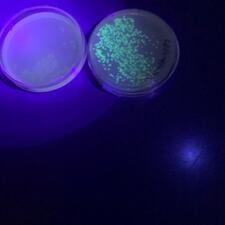

News from the Nest - Nov.29-Dec.3
Spotlight on Learning: Students becoming Scientists!
Specialized Science 12 (Laboratory Practice) is a course designed to allow students to gain skills in the processes of science. The course is designed so that students get hands-on experience primarily in the fields of Chemistry and Biology, but other science disciplines are explored. Recently, students worked for three days to use their knowledge and skills to genetically engineer bacteria to glow. Students studied gene expression and gene regulation and followed protocols to be able to alter the DNA of the bacteria. All students were able to modify their bacteria samples to be able to glow!
Student Quote: “This is an opportunity we would never get in any other course! This course teaches us practical lab skills at a post-secondary level.” - Juliana Su and Keira Thompson
Rock Your Mocs and the Winner is . . .
[A group of people posing for a photo Description automatically generated] A big shout out to our Inclusion class and EAs including the Teacher for Inclusion, Cassy Crawford. They jumped into the colouring contest challenge for Roc Your Mocs day and won a hot chocolate & donuts party for their class. Thank you to the 8 classes who participated in the Roc your Mocs Kahoot. This event was created to help instill Indigenous pride. In the background of one photo, you can see the beautiful dream catcher craft that the students made. The students listened to the story from Sam, the ISW here at Mouat. She told them how the dream catcher was a gift from a spider. Typically, dream catchers are received as a gift and then hung over your bed. At night while you sleep, its job is to block all the bad dreams from coming your way the same way that flies are caught in a spider's web. Also, the center of the dream catcher has an open circle. It is through this circle that all the good dreams stream towards you. Drop us an email or pop by sometime to discuss different ways that Indigenous students, ways, knowledge, and content can be supported in your class.
Our Character Word of the Month is TEAMWORK
Affirmation: I am a team player. I work and play well with others. I respect the expectations. I keep myself and others safe.
Rocket League
Our Rocket League (e-sports team) finished 4th in regular league play out of 24 teams. Playoffs for our e-sports participants begin December 7. Go Hawks!
Ms. White – THANK YOU from UBC
This week we received an extensive email from R. Taylor, UBC, Director of Bands, thank Ms. White. In his words: “I am writing with tremendous gratitude to you and the wonderful students under your mentorship in the Extended Day Art program. It was an absolute delight to collaborate with you in every respect, and I commend your creativity, dedication, professionalism, communication, and passion for teaching and learning. The artwork the students created for our Nov 19 concert at the Chan Centre for the Performing Arts was out-of-this-world amazing! So many audience members who saw the performance in person or through the online livestream commented on the quality of the technique and depth of expression by these young artists. I truly enjoyed “meeting” you all in our short Zoom session and getting to know the students through their wildly creative submissions. I can’t wait for the opportunity to collaborate again and hope we can aim for a more interactive project that involves Extended Day Art, Janet’s wonderful music students, and the UBC Bands. Thank you, Ms. White, for the passion and going above and beyond!
Elements @ Clay Cottage
Mouat's ELEMENTS group channeled their creativity at Clay Cottage this past week. Way to go girls! Huge thank to you to each of the team for being outstanding ambassadors for the school. Shout out to the staff who all pitched in to get the crew to and from.
Calendar:
- All Week:
- Food Drive
- Basketball Intramurals
- Monday, Nov. 29
- ABCD
- Just Dance Intramurals
- Sr. Boys BBall @ Tweedsmuir
- Tuesday, Nov. 30
- CDAB
- Key Club Donut Fundraiser Delivery
- Sr. Boys BBall vs Centennial 7pm
- Wednesday, Dec. 1
- BADC
- Jr. Girls BBall vs Hansen 5:30
- Jr. Boys BBall vs Hansen 7pm
- Thursday, Dec. 2
- DCBA
- 12 Days of Christmas
- Sr. Boys BBall Tournament
- Sr. Girls BBall Tournament
- Friday, Dec. 3
- DCBA
- 12 Days of Christmas
- Sr. Boys BBall Tournament
- Sr. Girls BBall Tournament